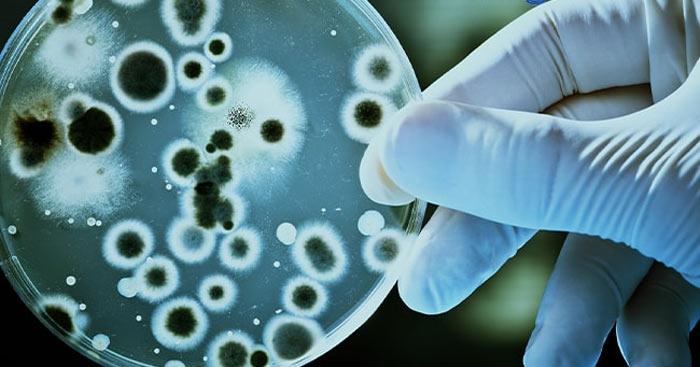
Phân biệt nuôi cấy liên tục và nuôi cấy không liên tục                                   So sánh nuôi cấy liên tục và không liên tục

Các mức phạt cho lỗi chở hàng cồng kềnh trên xe máy năm 2025
Trong đó, tại điểm e khoản 3 Điều 7 Nghị định 168/2024/NĐ-CP quy định về xử phạt, trừ điểm giấy phép lái của người điều khiển xe mô tô, xe gắn máy, các loại xe tương tự xe mô tô...
Phân biệt nuôi cấy liên tục và nuôi cấy không liên tục So sánh nuôi cấy liên tục và không liên tục
Phân biệt nuôi cấy liên tục và không liên tục là một trong những kiến thức trọng tâm trong chương trình Sinh học lớp 10. Tuy nhiên nhiều bạn học sinh vẫn chưa nắm vững được các phân biệt. Vì...
Đề thi học sinh giỏi tiếng Anh lớp 7 – Tổng hợp kiến thức thường gặp
Bài viết này giới thiệu các chủ điểm kiến thức thường gặp trong đề thi học sinh giỏi tiếng Anh lớp 7, bao gồm ngữ pháp, trường từ vựng, ngữ âm và các chiến lược giải quyết hiệu quả các...
Lời chúc Chủ nhật, stt về Chủ nhật vui vẻ, tràn đầy yêu thương
Lời chúc ngày Chủ Nhật thế nào để gây ấn tượng với người đọc. Bài viết sẽ tổng hợp cho bạn những lời chúc Chủ Nhật hay và thú vị nhất.Chào mừng đến với bộ sưu tập lời chúc Chủ...
Chi tiết mức học phí các trường thành viên, đơn vị trực thuộc ĐH Quốc gia Hà Nội
Đến thời điểm hiện tại, Đại học Quốc gia Hà Nội đã công bố thông tin học phí của các trường đại học thành viên và các đơn vị trực thuộc. Học phí tại Trường Đại học Khoa học Tự...
KW là gì? Phân biệt giữa kW và kWh
KWlà một thuật ngữ thường được sử dụng trong ngành điện. Đây là viết tắt của “kilowatt,” một đơn vị đo công suất. Để hiểu rõ hơn về KW, chúng ta cần phân biệt giữa kW và kWh, hai khái...
Bài 1, 2, 3, 4, 5 trang 34, 35 Bài 9 tiết 3 Vở bài tập (VBT) Toán lớp 5 tập 1 - Kết nối tri thức
Bài 1 trang 34 Vở bài tập (VBT) Toán 5 - Kết nối tri thức tập 1 Ước lượng kết quả phép tính rồi viết số thích hợp vào chỗ chấm. a) Kết quả phép tính 13 010 - 8...
Top 10 Giải Nhất cuộc thi vẽ tranh "Ngôi nhà mơ ước" năm 2024
Cuộc thi được tổ chức bởi Tạp chí Trẻ em Việt Nam - cơ quan ngôn luận của Hội Bảo vệ quyền trẻ em Việt Nam phối hợp với Văn phòng phẩm Eras, là sân chơi bổ ích, thiết thực,...
Hai đứa trẻ - Thạch Lam
II. Tác phẩm 1. Tóm tắt Truyện xoay quanh hai đứa trẻ Liên và An. Chúng đã từng có một cuộc sống đầy đủ vui vẻ ở Hà Nội. Do gia đình sa sút, hai đứa trẻ phải về...
Ngày Giải phóng miền Nam tiếng Anh là gì? Học từ vựng, bài hát tiếng Anh về ngày 30/4
Trang chủ » GIẬT 3 TẦNG QUÀ - IN DẤU TIẾNG ANH Ở Việt Nam ngày giải phóng miền Nam là ngày vô cùng trọng đại, là ngày lễ quốc gia (Public holiday) của Việt Nam....
Điều kiện tối thiểu để thành lập chi Đoàn là gì?
1. Thế nào là chi Đoàn? Chi Đoàn là tế bào của tổ chức cơ sở Đoàn Thanh niên Cộng sản Hồ Chí Minh, nơi tập hợp thanh thiếu niên, là hạt nhân nòng cốt cho sự đoàn kết...
“Hai chân, ba mũi giáp công” giành quyền làm chủ
QĐND - Trước âm mưu mới của Mỹ và chính quyền Việt Nam Cộng hòa đẩy mạnh “chiến tranh cục bộ”, đưa quân Mỹ vào trực tiếp tham chiến trên chiến trường, đầu năm 1964, Tỉnh ủy Phú Yên đề...
Lời chúc cuối tuần cho người yêu ngọt ngào và lãng mạn
Lời chúc cuối tuần cho người yêu là điều bạn đang kiếm tìm? Bài viết sẽ tổng hợp cho bạn những lời chúc cuối tuần vui vẻ cho người yêu hay và đáng nhớ nhất.Cuối tuần là thời gian đặc...
Ơi Cải về đâu! – Truyện ngắn Nguyễn Ngọc Tư
Vanvn- Đoàn ca múa nhạc giải tán, thằng Quách Phú Thàn dẫn ông già Năm Nhỏ về ngã ba Sương, Thàn có nhỏ bồ mới quen bán quán ở đó. Con nhỏ tên Diễm Thương, nghe hay, mà khuôn mặt...